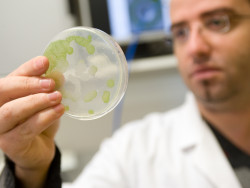
p016345001301.jpg

Etsi
Turun yliopiston edelle kiilasi kevään yhteishaussa Tampereen uusi yhteisyliopisto toiseksi suosituimpana yliopistona.

Se joka keväinen paniikki

Turku Future Sports -projektin tavoitteena on edistää turkulaisten liikkumista ja hyvinvointia sekä lisätä Turun kilpailukykyä ja vetovoimaa kehitt

Toukokuu huipentui sunnuntaina 26.5. europarlamenttivaaleihin.

Copernicus on vuodesta 2004 lähtien toiminut EU:n ohjelma, jonka tarkoituksena on kehittää satelliittihavaintoihin perustuvia tietopalveluja.

EU:n Luova Eurooppa -ohjelmasta rahoitetaan audiovisuaali-, kulttuuri- ja luovia aloja.

Euroopan tutkimus- ja innovaatiopäivien tarkoituksena on keskustella ja muodostaa tulevaisuuden tutkimus- ja innovaationäkymiä.

Vuoden 2019 Nordic Edge Expo & Conferencen teemana on Life Actually. Tällä halutaan viestittää sitä, että vaikka teknologia on muutoks

Vaikka työllisyys Euroopassa on kasvanut ja nuorten asema työmarkkinoilla parantunut, on nuorisotyöttömyys edelleen suuri ongelma Euroopassa.

Horisontti Eurooppa -puiteohjelman toisen pilarin alle kuuluvia missioita tulee olemaan yhteensä 5-10 kappaletta, ja niillä jokaisella on oltava se

Havainnekuva Turun Tiedepuisto Masterplan, Cederqvist & Jäntti Arkkitehdit Oy

Jätehuoltolautakunnan viranomaistehtäviin kuuluu alueen jätehuoltomääräyksistä ja maksuista päättäminen.

Opiskelijajärjestöt nauttivat kesästä latautuen syksyyn

Info- ja verkostoitumistilaisuuksissa esitellään Horisontti 2020 -ohjelman rahoitusmahdollisuuksia, edesautetaan konsortioiden perustamista sekä ke
Messut järjestetään torstaina 29.8.2019 klo 10–16 ICT-Cityssä. Messut ovat ilmaiset sekä näytteilleasettajille että kävijöile.

Uudet perinteet rikastavat vappua

Euroopan parlamentin vaalit järjestetään kuukauden kuluttua, Suomessa varsinainen vaalipäivä on 26.5. ja ennakkoon voi äänestää 15.-21.5.

Varsinais-Suomi on saanut nykyisestä EU:n tutkimus- ja innovaatiopuiteohjelmasta yhteensä yli 52,1 miljoonaa euroa, mikä on 5,8 %

Ensi kaudella Euroopan parlamentin voimasuhteet tulevat hyvin todennäköisesti menemään uusiksi.

Komissio julkaisi esityksensä tulevasta rahoituskehyksestä toukokuussa 2018.

EU haluaa olla tekoälyn kehittämisen ja käyttöönoton etulinjassa säilyttääkseen kilpailukyvyn ja turvatakseen tekoälyn eettisen kehityksen.

YK:n kestävän kehityksen tavoitteet vuodelle 2030 ovat olleet erityisen pinnalla EU-keskustelussa sen jälkeen, kun komissio julkaisi tammikuussa po

Toukokuun vaalien jälkeen parlamentti pitää ensimmäisen järjestäytymisistuntonsa 2.-4.

SEABASED (Seabased measures in Baltic Sea Nutrient Management) on vuoden 2018 maaliskuussa alkanut hanke, joka on rahoitettu pääos

Sivut
- « ensimmäinen
- ‹ edellinen
- …
- 51
- 52
- 53
- 54
- 55
- 56
- 57
- 58
- 59
- …
- seuraava ›
- viimeinen »
